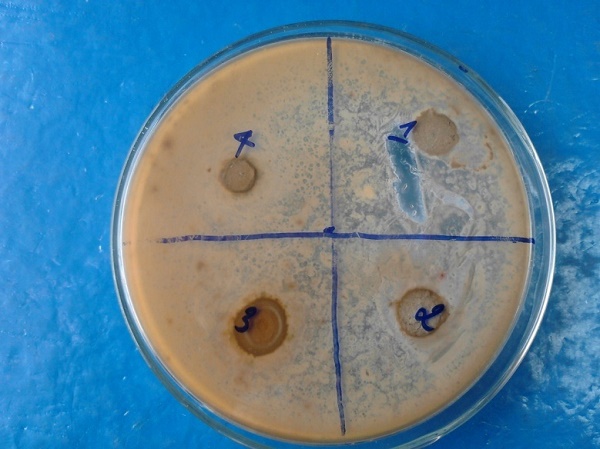

Hình ảnh Bentonit thô (A) và Bentonit sau tinh chế (B)
Ở nước ta, mỏ benonite nằm rải rác ở nhiều địa phương, mỏ lớn nhất đã được phát hiện tại Tây Nguyên thuộc khu vực xã Tam Bố, huyện Di Linh, tỉnh Lâm Đồng. Cho đến nay, bentonite mới được sử dụng để làm nguyên liệu sản xuất dịch khoan cho ngành dầu khí, vì vậy chưa khai thác được hết lợi ích cũng như tiềm năng của nguồn nguyên liệu trên.
Nhằm sử dụng hợp lý nguồn tài nguyên thiên nhiên benonite, Viện Công nghệ môi trường (thuộc Viện HLKHCNVN) đã đề xuất và được giao thực hiện đề tài “Nghiên cứu đánh giá khả năng nâng cao giá trị sử dụng và xây dựng công nghệ chế biến bentonite Lâm Đồng làm phụ gia thức ăn cho gia cầm” trong Chương trình Tây Nguyên 3 từ tháng 11 năm 2012. Đề tài chủ yếu xoay quanh việc xây dựng quy trình tinh chế và biến tính bentonite tại Tam Bố để sử dụng kết hợp với nano bạc cũng do Viện Công nghệ Môi trường chế tạo, làm phụ gia thức ăn cho gia cầm.

Hình ảnh khảo sát lấy mẫu thực địa
Theo số liệu thu thập liên quan đến mỏ bentonite ở xã Tam Bố thì khu mỏ này có diện tích 2,65 km2 (khoảng 265 ha), đã khai thác được 30 ha với trữ lượng 400.000 m3. Trải qua hai chuyến khảo sát tại hiện trường, phối hợp với các cán bộ khoa học Viện Địa chất (Viện HLKHCNVN), đoàn công tác Viện Công nghệ môi trường đã thu thập tại chỗ hơn 30 mẫu khoáng sét bentonite. Các mẫu này được tập hợp đưa vào phân tích thành phần hóa học và khoáng vật để xây dựng cơ sở dữ liệu, lập bản đồ nguồn nguyên liệu phục vụ cho việc tìm nguyên liệu thích hợp chế biến thành phụ gia thức ăn gia cầm.
Trên cơ sở các nghiên cứu thực nghiệm, nhóm thực hiện đề tài đã xây dựng được phương pháp xử lý ướt kết hợp với công nghệ tuyển trọng lực để tinh chế một số mẫu bentonite đã thu thập được. Ở thời gian trương nở thích hợp và sử dụng máy tách Xyclon, phương pháp này đã tinh chế nguyên liệu khoáng sét bentonite thô có hàm lượng khoáng MMT ban đầu khoảng 50% thành bentonite tinh đạt hàm lượng khoáng MMT lên tới 75%, đạt tiêu chuẩn làm nguyên liệu sản xuất phụ gia thức ăn chăn nuôi mà các nước ngoài thường sử dụng.
Dung dịch keo nano bạc 100ppm, 150 ppm, 200ppm, 250 ppm.
Cùng với việc tinh chế bentonite đạt chuẩn, Viện Công nghệ môi trường đã hoàn thiện 3 phương pháp hóa học chế tạo nano bạc có tính thân thiện và tương thích sinh học cao bằng các vật liệu hữu cơ không gây độc để cấy lên bentonite làm phụ gia thức ăn cho gia cầm. Nano Ag sau khi cấy vào bentonite tinh chế thành sản phẩm có khả năng hạn chế sự phát triển của các loài nấm mốc tiết ra các độc tố thường phát triển trên môi trường thức ăn cho gia cầm. Bentonite hấp thụ các độc tố nấm hiện diện trong thức ăn, tăng sự cân bằng các chất điện giải trong cơ thể, thải ra ngoài các sản phẩm độc hại của quá trình tiêu hóa, giúp điều hòa ổn định quá trình sinh trưởng và sinh sản đối với gia cầm.

Ảnh SEM của chế phẩm Bentonit Lâm Đồng gắn nano Ag
Hình ảnh thử nghiệm vòng kháng khuẩn (A) và hạn chế sự phát triển của nấm (B) của Bentonit gắn nano Ag.
Qua đó, quy trình công nghệ biến tính thích hợp để chế biến bentonite Lâm Đồng thành phụ gia thức ăn gia cầm đã dần đi vào hoàn chỉnh. Bentonite được điều chế theo công nghệ của Viện Công nghệ môi trường không chỉ mang những đặc tính thích hợp bổ sung vào thức ăn chăn nuôi, làm tăng sản lượng vật nuôi mà còn đem lại hiệu quả kinh tế cao và hứa hẹn góp phần đẩy mạnh sự phát triển của ngành chăn nuôi tại Việt Nam.
PGS. TS Nguyễn Hoài Châu – Viện Công nghệ môi trường
Nguồn: Viện Hàn lâm KH&CN Việt Nam